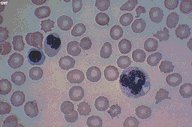

Description
This is a Wright's stained peripheral blood smear
in a patient with acute non-lymphoblastic
leukemia, FAB classification M6. A very abnormal
neutrophil is seen in the right and two abnormal
nucleate erythroid precursors are seen on the
left. There is significant burring and spurring of
some of the adult red blood cells as well as some
anisocytosis.
|
|
Click on this image
to enlarge it, then
on Back botton
in the Netscape Menu
to shrink it back down



|